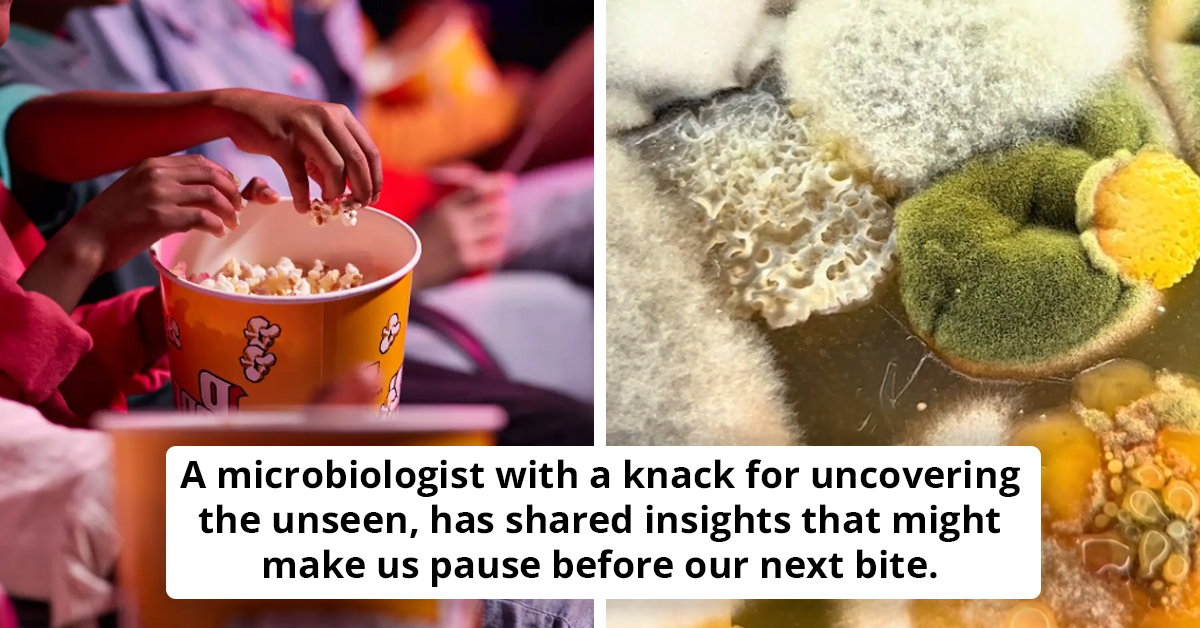
Beware Of The Snack: The Dark Side Of Cinema Popcorn
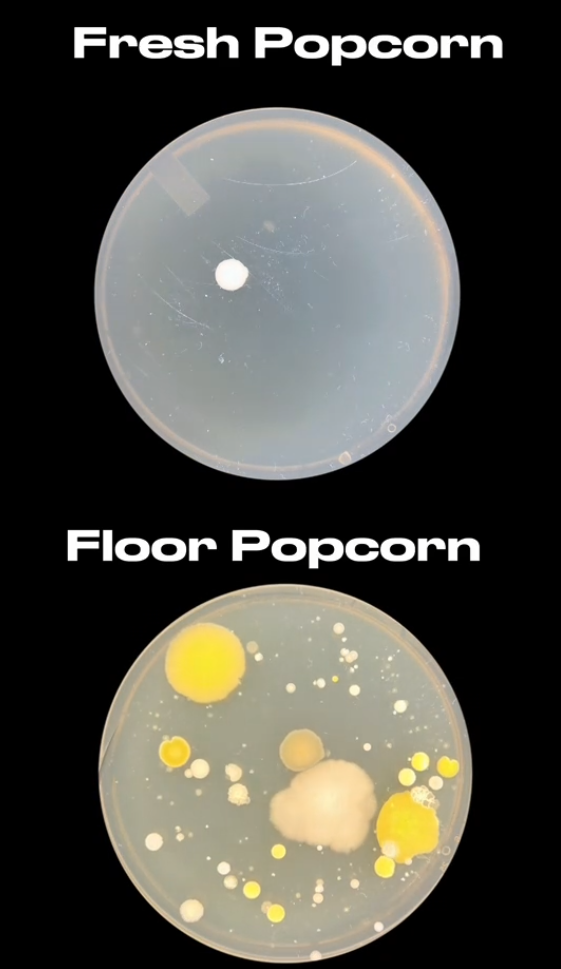
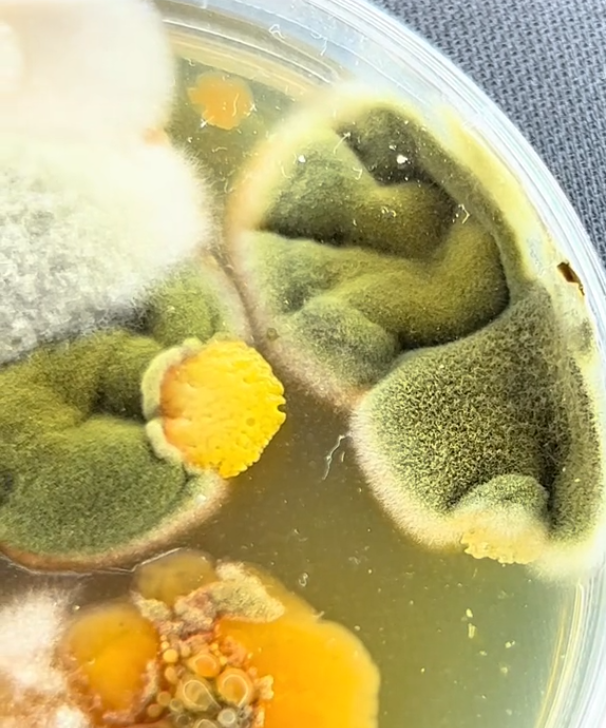

Beware Of The Snack: The Dark Side Of Cinema Popcorn
Discover what lurks in your favorite cinema snack. You'll never see popcorn the same way again!
Imagine settling into your cinema seat, the lights dim, and you reach for a handful of that irresistible popcorn. But what if I told you that your beloved snack harbors secrets, not just of flavor but of unseen guests?
A recent investigation by a curious microbiologist, Tim, has unveiled startling truths about the popcorn we thought we knew. His findings? A microscopic world thriving in those buttery kernels, both on the floor and, surprisingly, in the bag. This revelation might just change your movie-going rituals forever.

Heading to the movies is an experience many of us cherish, especially the part where we dive into a big bag of popcorn. However, Tim, a microbiologist with a knack for uncovering the unseen, has shared insights that might make us pause before our next bite.
Through his TikTok, @whatmightgrow, Tim embarked on a mission to explore what really accompanies our popcorn.
At the heart of this exploration was a simple yet eye-opening experiment. Tim collected samples of freshly served popcorn and those that had found their way to the floor. Back in the lab, these samples were introduced to petri dishes and left to reveal their secrets under the watchful eye of an incubator.
The outcome was nothing short of astonishing. The popcorn from the floor, as expected, was a breeding ground for bacteria and fungi, showcasing a variety of microbial life. But the real shock came from the "fresh" popcorn. Although less contaminated, it wasn't free from bacteria, suspected to be Staphylococcus, a common human companion.

Tim's experiment sheds light on a broader truth: the invisible world of microbes is all around us, even in places we consider safe or clean. His findings on cinema popcorn are a testament to this, challenging the comfort we find in our favorite snacks.
The implications of Tim's work extend beyond the cinema. It's a call to reconsider our habits and the often-overlooked reality of bacteria and pathogens in our environment. So, the next time you're about to apply the five-second rule or indulge in a bag of popcorn, remember Tim's experiment. It's a reminder of the microscopic world that thrives unseen and the caution we should exercise in our daily lives.

In a world where cleanliness is more important than ever, this discovery is a wake-up call. It's not just about avoiding floor popcorn; it's about recognizing the unseen risks that lurk in even the most mundane aspects of our lives. As we move forward, let's keep our eyes open and our habits in check, ensuring our health and safety in a world teeming with microscopic life.





